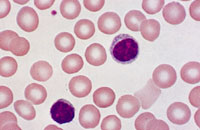
043.jpg 043.jpg

Mobile Bible, Bible Information, Mobile iWorship, 성경연대표 1.창조 2.족장 3.출애굽 4.광야 5.정복 6.사사 7.통일왕국 8.분열왕국 9.포로 10.포로귀환 11.중간 12.예수 13.초대교회 14.세계선교 구글 Map 성경66권 사전 : 창-출(레)-민(신)-수-삿(룻)-삼(상,하)-왕(상,하)-대(상,하)-라(에)-느-중간-(마.막.눅.요)-행
탈무드, 창조과학, 단테의 신곡, 동영상강의 및 기독교뉴스
엡04:29 무릇 더러운 말은 너희 입밖에도 내지 말고 오직 덕을 세우는데 소용되는 대로 선한 말을 하여 듣는 자들에게 은혜를 끼치게 하라
| 인체의 신비 |
![]()
세균이나 바이러스 한 마리만 해도 생명의 신비가 그와 같이 엄청난데, 하물며 만물의 영장인 사람은 오죽하겠는가? 한 예로써, 사람은 백조(1014)개의 세포로 구성된, 세포의 대 연방공화국이며, 이 세포 1개만 해도 대장균이 가지는 정보의 수천만 배가 넘으며 이 모든 생명의 정보가 어떠한 컴퓨터보다 더 질서정연하게 기능을 수행하고 있다.
이 수식을 컴퓨터를 이용하여 그래프로 그려보았더니 오른 쪽 그림과 같은 단면도가 나왔고, 이것을 토대로 입체모형을 만든 것이 아래 그림에 있는 도우넛 모양의 붉은 원판이다.
그런데 이것은 인체 혈관 속에 무수히 많이 존재하는 적혈구의 구조와 꼭 같다(아래 그림).
인체의 신비에 대해서 더 상세한 것을 알고자 하는 분들은 김종배 박사가 지은 '신비한 인체 창조섭리 (국민일보사)'와 폴 브랜드 박사가 지은 '오묘한 육체 (생명의 말씀사)'를 참조하시라. 컴퓨터 과학자들은, 정보란 아무리 오랜 시간이 지나도 결코 저절로 생겨나지 않는다는 사실을 밝혔다. 그런데 이 컴퓨터보다 훨씬 정교하고 복잡한 생명의 정보가 저절로 생겨날 수는 결코 없다. 오히려 초자연적 지혜의 개입을 인정하지 않을 수 없는 것이다. |
서민호 교수([email protected])의 창조과학에서 ( http://wonderfuldesign.com/ )
서민호 교수의 창조과학 - 생명의 신비
BIBLE - WEB,
KJV,
ASV(Quiz),
NIV,
개역한글KHRV(
120일1독,
1년1독,
권별,
성경통독
)
STUDY - 구절(WESLEY),
단락(MATTHEW),
테마별,
읽기(Wayne),
소요리,
대요리 문답,
신앙고백WCF
Dictionary - Chapter,
OT구약,
NT신약,
성경연대표
1.창조
2.족장
3.출애굽
4.광야
5.정복
6.사사
7.통일왕국
8.분열왕국
9.포로
10.포로귀환
11.중간
12.예수
13.초대교회
14.세계선교
|